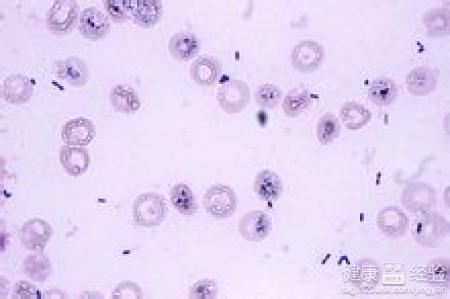
第1步

新生兒敗血症(終結),出於什麼原因
概 述
新生兒敗血症是一種由於病原體的的入侵對新生兒機體造成嚴重的感染性疾病。其臨床症狀表現不典型,一般為反應差、嗜睡、發熱、體溫不升、少吃、少哭、不動等。其可引起的症狀可有黃疸新、肝脾腫大、出血傾向、休克等,也可合並肺炎、腦膜炎、壞死性小腸結炎、化膿性關節炎和骨髓炎等。所以新生兒敗血病應及時治療,一旦延誤最佳治療時間,其後果相當嚴重。
步驟/方法:
1我國新生兒敗血症病原菌多為葡萄球菌,其次為大腸埃希菌等革蘭陰性菌,一些真菌、病毒或原蟲也可引起新生兒敗血症。這些病原體通過入侵新生兒的血液循環系統,並在血液中生長、繁殖、產生毒素從而造成其全身性炎症反應。
2由於新生兒剛剛出生,其屏障功代替能差,淋巴系統發育不完全,經典及補體途徑的部分成分含量低,中性粒細胞生產及含量不足等原因使得新生兒對感染的病原體不能及時處理也較易受到病原體入侵引起新生兒敗血症。

3新生兒敗血症可分兩種,一般以一周為界,小於出生後一周起病的為早型,大於一周的為晚型。早型病原菌多以大腸埃希菌為主,而晚型多以葡萄球菌為主。早型的死亡率大於晚型。臨床可通過可通過細菌學檢查和非特異性檢查進行確診。
注意事項:
體內新生兒免疫球蛋白主要來自母體,所以體內免疫球蛋白的含量與胎齡息息相關,因此胎齡越小患新生兒敗血症的風險就越高。這也是對於有早產史的孕婦在分娩過程中采取預防性應用抗生素措施的原因之一。
- 上一頁:新生兒低燒、鼻塞要吃些什麼藥
- 下一頁:新生兒打呼噜什麼原因
- 關於新生兒
-
碘的作用與用途
作用與用途 碘對動植物的生命是極其重要的。海水裡的碘化物和
-
寶寶兩歲多了還在使勁的流口水怎麼辦?
寶寶兩歲多了還在使勁的流口
-
寶貝能不能喝豆漿機打的米糊啊
寶貝能不能喝豆漿機打的米糊啊
-
多動症對孩子的危害有多嚴重
概 述 多動症這種情況在我們的生活當中是





